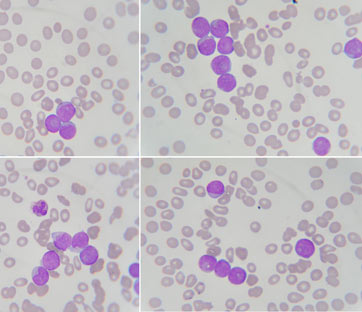

Contro la leucemia globuli bianchi OGM
Globuli bianchi geneticamente modificati, le cellule stesse del nostro sistema immunitario. Potrebbe essere questo il futuro nel trattamento di alcuni tipi di leucemia. “Si tratta di un metodo di cui si parla da qualche anno – sottolinea Gianpietro Semenzato, oncoematologo dell’università di Padova – che potrebbe portare a una terapia alternativa alla chemioterapia”. Un passo avanti significativo se si pensa agli effetti collaterali che questa comporta, come la perdita dei capelli e delle ciglia, la stanchezza, la nausea e il vomito solo per citarne alcuni. Una ulteriore conferma della validità di questa nuova cura è arrivata proprio nelle scorse settimane da uno studio clinico coordinato da Stephan Grupp del Children’s Hospital of Philadelphia in collaborazione con l’University of Pennsylvania, pubblicato su The New England Journal of Medicine.
Nel caso specifico i pazienti soffrivano di leucemia linfoblastica acuta. Una malattia, diffusa soprattutto tra i bambini, in cui i linfociti T o B, due tipi di globuli bianchi che hanno origine nel midollo osseo, vanno incontro a una trasformazione tumorale e proliferano nel sangue, nel midollo stesso, nel fegato nel sistema nervoso centrale. I medici hanno dunque sottoposto al trattamento 30 persone, 25 delle quali di età compresa tra i 5 e i 22 anni e cinque tra i 26 e i 60.
In che cosa consiste dunque la terapia? Dal sangue del malato vengono prelevati i linfociti T e, attraverso processi di ingegneria genetica, sono indotti a esprimere sulla loro superficie delle particolari proteine, dette recettori chimerici (chimeric antigen receptor). In questo modo, armati di tutto punto, i linfociti sono in grado di riconoscere il “segnale di pericolo” sulla cellula cancerogena, l’antigene, e di andare quindi a eliminare il tumore. Nel trial clinico coordinato da Grupp l’antigene da individuare è la proteina CD19. Dopo essere stati coltivati in laboratorio fino a ottenerne a miliardi, i linfociti geneticamente modificati vengono reinfusi nel malato dove iniziano a moltiplicarsi e a svolgere la loro funzione. Grazie al recettore chimerico sono in grado di esercitare anche una seconda azione andando ad agire sul microambiente circostante il tumore e potenziando in questo modo, attraverso la secrezione di citochine, l’attività delle cellule immuni presenti. Ebbene al termine della terapia in 27 dei 30 pazienti, monitorati per due anni, si è assistito alla scomparsa del tumore.
Certo gli scienziati non tacciono i possibili effetti collaterali del trattamento. Il più significativo è stato proprio il considerevole aumento nel livello delle citochine, i mediatori intracellulari che controllano la crescita e il differenziamento cellulare, la risposta immunitaria e l’infiammazione. Una condizione, provocata dalla proliferazione dei linfociti T, che può indurre nel malato ipotensione, insufficienza renale e respiratoria, alterazioni nel meccanismo di coagulazione del sangue. Nei pazienti esaminati dal team di Stephan Grupp, la cosiddetta sindrome da rilascio di citochine si è manifestata con febbre e mialgie che si sono tuttavia risolte spontaneamente nel giro di pochi giorni. Circa il 30% dei pazienti invece ha manifestato sintomi più gravi, quali ipotensione e insufficienza respiratoria.
Il trattamento con linfociti T geneticamente modificati è stato sperimentato inizialmente su un piccolo gruppo di pazienti con leucemia linfatica cronica e i risultati, pubblicati nel 2011, furono positivi. Successivamente quindi il metodo fu esteso anche ai malati di leucemia linfoblastica acuta a cellule B recidivante e refrattaria. A lavorarci da un lato ancora Grupp con la sua équipe, dall’altra il team di Renier J. Brentjens al Memorial Sloan Kettering Cancer Center di New York. Anche in questo caso, sebbene la sperimentazione sia stata condotta su pochi individui, i due trial clinici videro una positiva risposta dei pazienti alla terapia. Nel 2013 gli studi furono pubblicati rispettivamente su The New England Journal of Medicine e su Science Translational Medicine.
Nonostante i risultati incoraggianti gli scienziati sono tuttavia cauti, riporta il National Cancer Institute. La sperimentazione clinica è ancora agli inizi e la strada da fare è molta. “Abbiamo bisogno di trattare un numero maggiore di pazienti – sottolinea Grupp – e di monitorarli per un periodo più lungo per poter dire quale sia realmente l’impatto di questa terapia e per capire la sua vera efficacia”. Ma non si può trascurare che si tratta di una cura che potrebbe rivelarsi particolarmente importante per le persone in cui la leucemia torna a manifestarsi nonostante il ricorso a chemioterapia intensiva o al trapianto di staminali, dato che in questi casi le possibilità rimanenti sono quasi nulle.
“La ricerca oggi sta percorrendo questa strada – spiega Semenzato – e l’obiettivo è di sostituire la chemioterapia con i cosiddetti farmaci intelligenti. Questo perché la chemioterapia, andando ad agire sia sulle cellule malate che su quelle sane, produce effetti collaterali non trascurabili, mentre i farmaci su cui ci si sta concentrando colpiscono selettivamente il bersaglio molecolare”. Nel caso specifico si cerca di aggredire il tumore sfruttando le possibilità del sistema immunitario, un sistema che potrebbe risultare utile non solo nel caso delle leucemie ma anche di altre malattie oncoematologiche.
Semenzato spiega che già oggi, per alcuni tipi di linfomi, esistono alternative alla chemioterapia come ad esempio il trattamento con anticorpi monoclonali, specifici cioè per determinati antigeni espressi sulla cellula tumorale. O ancora si ricorre da tempo agli inibitori delle tirosin-chinasi (enzimi che regolano i processi di attivazione cellulare) per curare la leucemia mieloide cronica.
Si tratta di possibilità che non esistono ancora nel caso della leucemia linfoblastica acuta o cronica per la quale i chemioterapici rimangono l’unica strategia terapeutica possibile. Fatte salve le prospettive che da qualche anno sembra aprire la ricerca.
Monica Panetto









